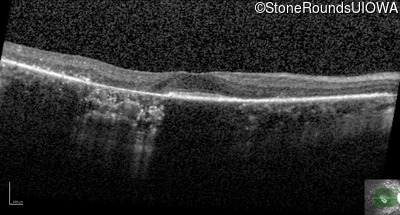
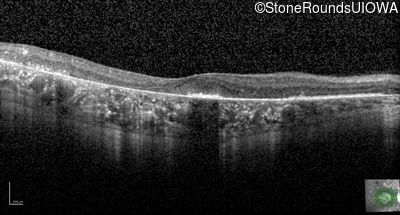

Case
SR3065
Student Mode
AD Retinitis Pigmentosa (IA1aii)
Female
Female
Hidden
SR3065
Student Mode
AD Retinitis Pigmentosa (IA1aii)
Female
Female
History
This 63 year old woman has had normal vision for most of her life, but recently developed difficulty seeing in dim light.
| Age at visit: 63 years |
Diagnosis & molecular findings
| Disease | Gene | Allele 1 variant(s) | Allele 2 variant(s) | Inheritance mode |
|---|---|---|---|---|
| AD Retinitis Pigmentosa | SAG | Cys147Phe TGT>TTT | AD |